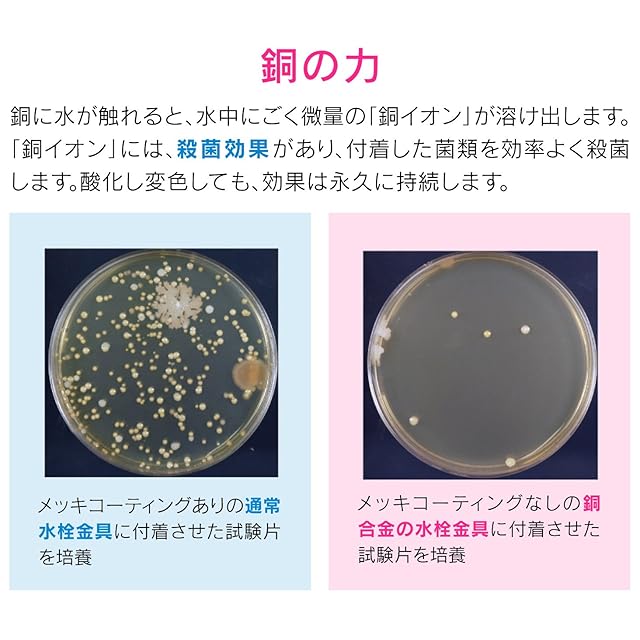

1/8
ガオナ これカモ シンク用 銅製ゴミカゴ 排水口のゴミ受け (殺菌効果 ヌメリ・臭い防止 衛生的) GA-PB012
¥10,354
International shipping available
【商品概要】
pattern:ゴミカゴのみ:
直径:144ミリ×高さ:44.5ミリ
素材・材質:銅
生産国:日本
使用を重ねるうちに黒ずんでいき、しだいに薄青みがかった皮膜に変色しますが、銅イオンの殺菌効果は変わりません。
直径144ミリのキッチンシンク用浅型ゴミカゴです。
pattern:セット:
ゴミカゴ直径:144ミリ×高さ:44.5ミリ、フタ直径:144ミリ×厚み:17ミリ
素材・材質:銅
生産国:日本
使用を重ねるうちに黒ずんでいき、しだいに薄青みがかった皮膜に変色しますが、銅イオンの殺菌効果は変わりません。
キッチンのシンク用の排水口フタと浅型ゴミカゴのセット(直径145ミリ用)です。
pattern:フタのみ:
直径:144ミリ×厚み:17ミリ
素材・材質:銅
生産国:日本
使用を重ねるうちに黒ずんでいき、しだいに薄青みがかった皮膜に変色しますが、銅イオンの殺菌効果は変わりません。
キッチンのシンク用の排水口フタ(直径145ミリ用)です。
-
レビュー
(56)
最近チェックした商品
その他の商品